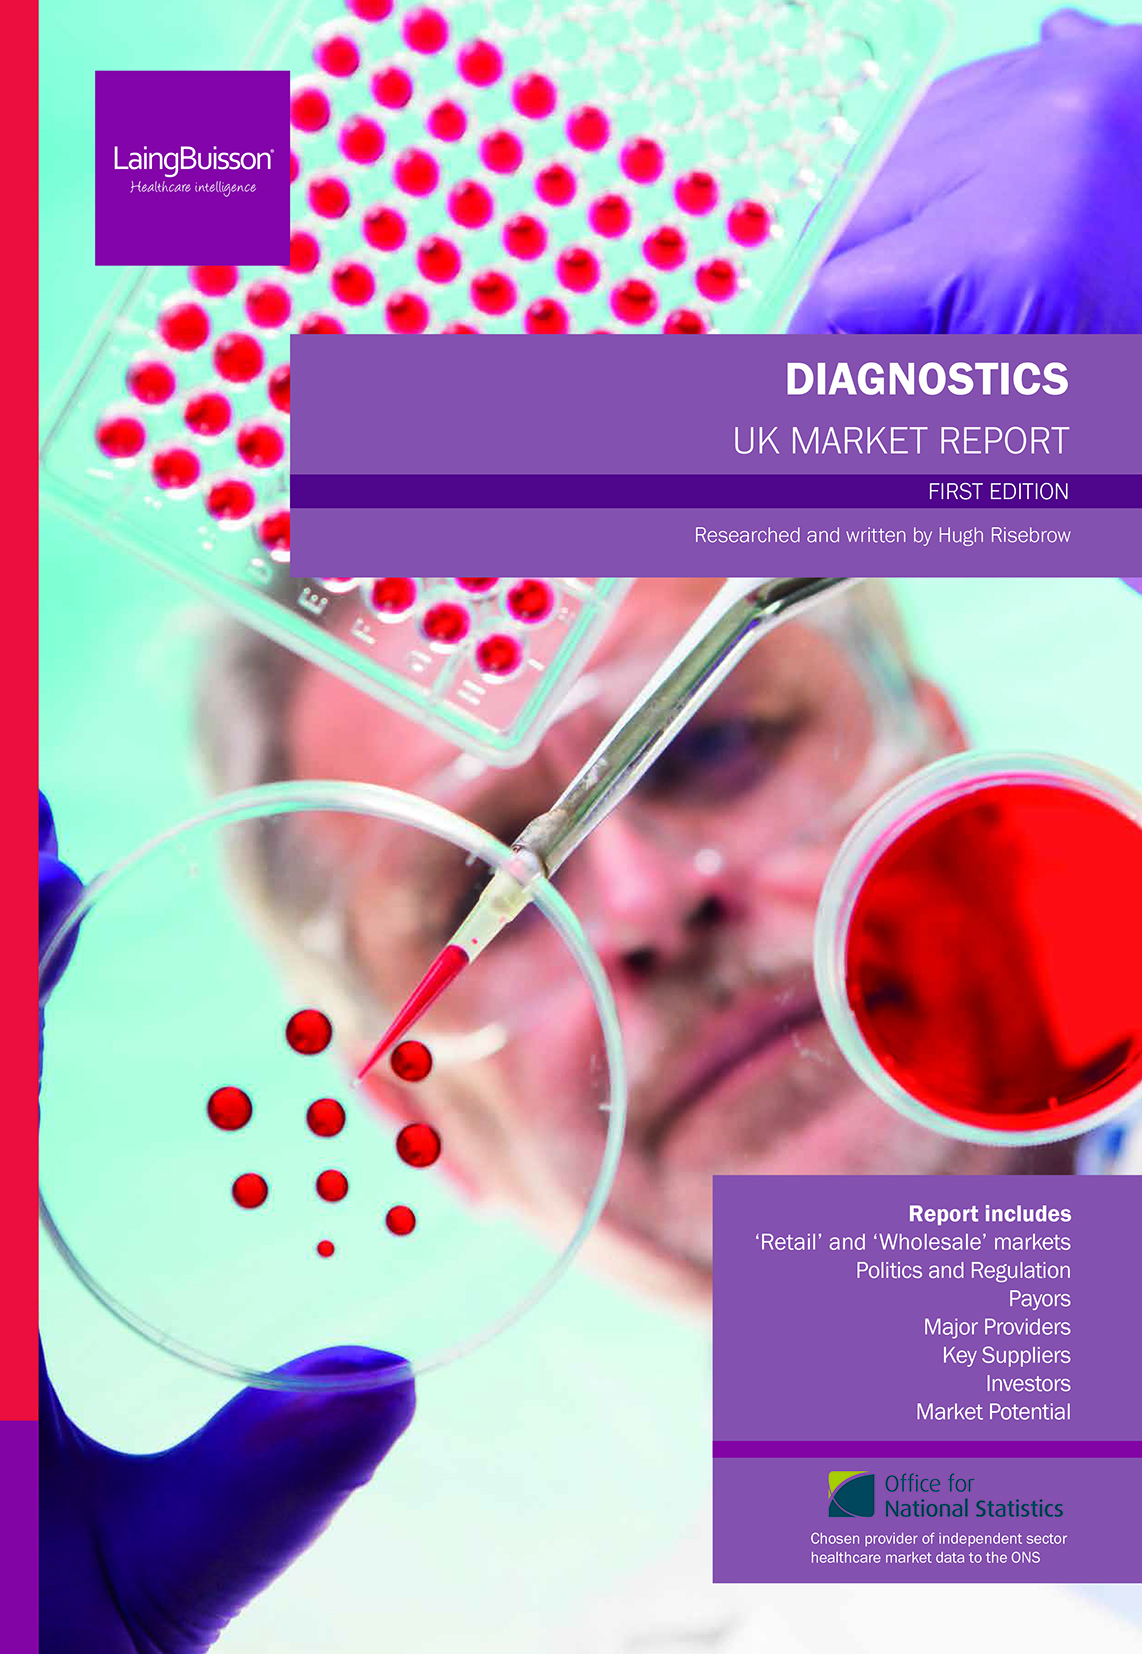
Diagnostics_1ed_CVR

I work with companies and individuals to create specialist sector market reports, annual reports and campaign publications.
I also work with clients to create infographics – both taking pre-chosen data points or through digging into editorial to pull out the elements which I believe will make the most eye-catching graphic for the readers.

Click below for examples…
Go Private Guide – a quarterly private healthcare promotional brochure
A Cry for Help – charity campaign report
Killing Time – a quirky independent horror movie magazine